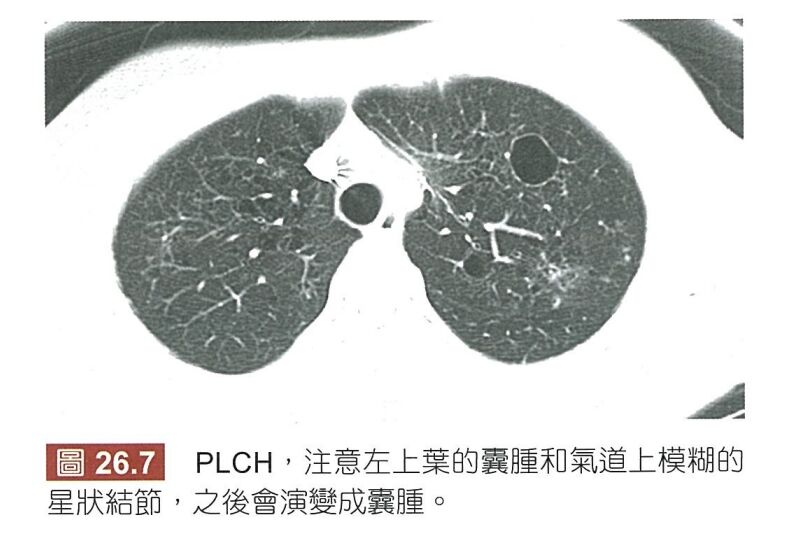

35.下列有關間質性肺病(interstitial lung disease)X 光影像之特性,何者錯誤?
(A)pulmonary Langerhans cell histiocytosis:上肺野為主要病灶區
(B)idiopathic pulmonary fibrosis:蜂巢狀肺(honeycomb lung)
(C)lymphangioleiomyomatosis:氣胸
(D)chronic hypersensitivity pneumonitis:下肺野為主要病灶區
答案:登入後查看
統計: A(17), B(10), C(26), D(56), E(0) #1054710
統計: A(17), B(10), C(26), D(56), E(0) #1054710